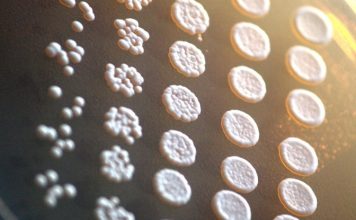

После землетрясения в Пакистане из воды поднялся необычный остров
Толпы людей собрались недоумением на южном побережье Пакистана, чтобы посмотреть на необычный новый остров, появившийся ...
Обнаружены новые детали о взаимосвязи плазмы и факторов старения
Предыдущее исследование относительно выявления потенциальной взаимосвязи между старением и состоянием кровяной плазмы п...
Разработан ультратонкий материал для производства электроэнергии
Группа ученых из университета Вандербильта разрабатывает ультратонкий материал, который может генерировать электричество...
Ученые создают бетон, который не будет разрушаться из-за реагентов
Соль действительно помогает очистить дороги ото льда зимой, но она также активно ухудшает их. Чтобы решить эту проблему,...
Ученые пересмотрели скелет Eusaurosphargis dalsassoi и сделали новые выводы
Еще в 2003 году в Италии были обнаружены окаменелые останки доисторического бронированного ящера, известного как Eusaur...
Здоровый сон обладает мощным эффектом антиоксиданта
Сегодня появилось новое исследование о сне в стенах Колумбийского Университета в США – ученые-нейробиологи продемонстри...
Марихуана и когнитивные способности: новое исследование
Исследования того, как именно марихуана и каннабиноиды в целом влияют на здоровье и отдельные когнитивные показатели че...
Шимпанзе не имеют лучших «человеческих» качеств
Международная группа ученых занимающихся приматами доказала, что альтруизм, также как и злорадство, шимпанзе не близок. ...
Чистка зубов может предупредить развитие синдрома Альцгеймера
Новое исследование из Университета Бергена о взаимосвязи развития нейродегенеративных заболеваний и плохой чисткой зубо...
Ученые объяснили причину сокращения численности некоторых видов животных
Конкуренция за места гнездования может объяснить, почему численность некоторых видов птиц и шмелей сокращается быстрее, ...